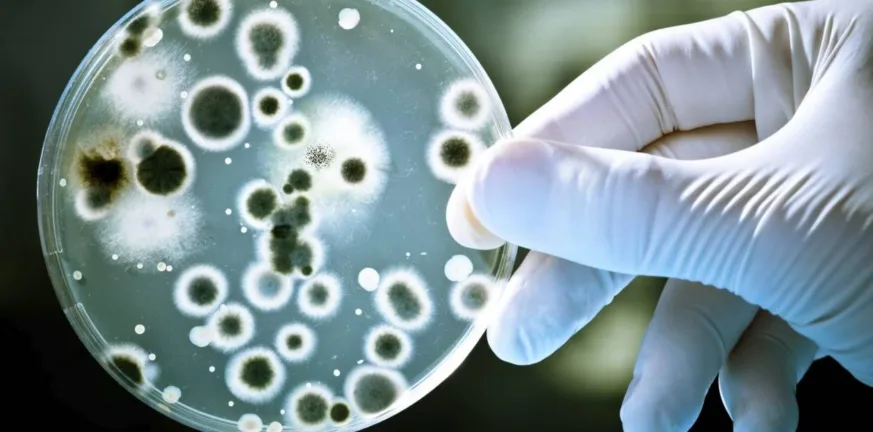

Παγκόσμιος Οργανισμός Υγείας: Η μεγάλη απειλή, η μικροβιακή αντοχή επιδεινώνεται με ταχύ ρυθμό
Τα νέα αντιβιοτικά δεν επαρκούν. Αν δεν υπάρξει δράση, οι θάνατοι από ανθεκτικές λοιμώξεις μπορεί να αυξηθούν κατά 60% έως το 2050
Τον κώδωνα του κινδύνου κρούει ο Παγκόσμιος Οργανισμός Υγείας (ΠΟΥ) για την απειλή της μικροβιακής αντοχής, η οποία αναμένεται να αυξήσει τους θανάτους κατά 60% έως το 2050. Στα τελευταία στοιχεία του αποτυπώνει τη δραματική εικόνα γύρω από τα αντιβακτηριακά φάρμακα που βρίσκονται στο στάδιο της (προ)κλινικής ανάπτυξης και τα διαγνωστικά τεστ που διατίθενται ή αναπτύσσονται.
Λίγα νέα φάρμακα – Περιορισμένη καινοτομία
Η ανάλυση του ΠΟΥ δείχνει ότι η «δεξαμενή» νέων αντιβακτηριακών είναι περιορισμένη και ανεπαρκής. Το 2023 υπήρχαν 97 φάρμακα σε κλινική ανάπτυξη, όμως φέτος ο αριθμός μειώθηκε στα 90. Από αυτά, μόνο τα 15 μπορούν να χαρακτηριστούν καινοτόμα, και μόλις 5 έχουν αποδειχθεί αποτελεσματικά έναντι βακτηρίων «κρίσιμης προτεραιότητας», της υψηλότερης κατηγορίας κινδύνου στη λίστα του.
Η εικόνα αυτή αποτυπώνει μια «διπλή κρίση»: Σπανιότητα και έλλειψη καινοτομίας. Επιπλέον, εξακολουθούν να υπάρχουν σημαντικά κενά, όπως τα από του στόματος φάρμακα για εξωνοσοκομειακή χρήση και οι συνδυαστικές θεραπείες που θα μπορούσαν να περιορίσουν την αυξανόμενη αντοχή.
Στον προκλινικό τομέα, 232 προγράμματα βρίσκονται σήμερα σε εξέλιξη διεθνώς, αλλά το 90% ανήκει σε μικρές εταιρείες με λιγότερους από 50 υπαλλήλους. Αυτό, όπως υπογραμμίζει ο ΠΟΥ, αναδεικνύει την ευθραυστότητα του οικοσυστήματος έρευνας και ανάπτυξης. Ο Οργανισμός καλεί τις εταιρείες και τα ερευνητικά κέντρα να δημοσιοποιούν δεδομένα για την αντιβακτηριακή δραστικότητα, προκειμένου να ενισχυθεί η συνεργασία, να προσελκυσθούν επενδύσεις και να επιταχυνθεί η καινοτομία.
Διαγνωστικά: Κρίσιμα κενά (και) στην πρώτη γραμμή
Εξίσου ανησυχητική είναι η εικόνα στα διαγνωστικά εργαλεία, ειδικά σε χώρες χαμηλού και μεσαίου εισοδήματος. Η σχετική έκθεση του ΠΟΥ καταγράφει επίμονα κενά, όπως:
απουσία πολυπαραμετρικών συστημάτων που να ανιχνεύουν άμεσα βακτηριαιμία από ολικό αίμα χωρίς καλλιέργεια,
ανεπαρκής πρόσβαση σε τεστ βιοδεικτών (π.χ. CRP, προκαλσιτονίνη) για να διακρίνουν βακτηριακές από ιογενείς λοιμώξεις,
έλλειψη απλών, οικονομικών τεστ «σημείου φροντίδας» για την πρωτοβάθμια και δευτεροβάθμια υγεία.
«Η μικροβιακή αντοχή επιδεινώνεται, αλλά η δεξαμενή νέων θεραπειών και διαγνωστικών παραμένει ανεπαρκής για να αναχαιτίσει την εξάπλωση των ανθεκτικών βακτηριακών λοιμώξεων», δήλωσε η Δρ. Yukiko Nakatani, Βοηθός Γενική Διευθύντρια του ΠΟΥ για τα Συστήματα Υγείας. «Χωρίς μεγαλύτερες επενδύσεις στην έρευνα και ανάπτυξη, μαζί με στοχευμένες προσπάθειες, ώστε τα νέα και υπάρχοντα προϊόντα να φτάνουν σε όσους τα έχουν μεγαλύτερη ανάγκη, οι λοιμώξεις αυτές θα συνεχίσουν να εξαπλώνονται».
Το ζητούμενο είναι η συντονισμένη δράση
Ο ΠΟΥ συνοψίζει ότι η μάχη κατά της μικροβιακής αντοχής απαιτεί άμεση, συντονισμένη δράση σε πολλά επίπεδα: από την ανακάλυψη νέων φαρμάκων και την καινοτομία στα διαγνωστικά, έως στρατηγικές δίκαιης πρόσβασης και νέα μοντέλα χρηματοδότησης, τα οποία θα στηρίξουν τις μικρομεσαίες επιχειρήσεις που πρωτοστατούν σήμερα στην έρευνα.
Η «Πελοπόννησος» και το pelop.gr σε ανοιχτή γραμμή με τον Πολίτη
Η φωνή σου έχει δύναμη – στείλε παράπονα, καταγγελίες ή ιδέες για τη γειτονιά σου.
Ακολουθήστε μας για όλες τις ειδήσεις στο Bing News και το Google News





